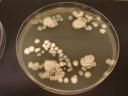
logo

En évoquant dans cette inquiétante déclaration la destruction de l’espèce humaine par un organisme génétiquement modifié, le physicien faisait écho à une préoccupation grandissante dans les milieux scientifiques et militaires : le génie génétique permet maintenant, en manipulant le génome des agents classiques de la guerre biologique - peste, maladie du charbon, tularémie, etc. -, de les rendre beaucoup plus dangereux qu’ils ne le sont déjà .
Cette idée s’est définitivement imposée en décembre 1997, quand, dans un article de la revue scientifique Vaccine, des savants russes ont expliqué comment ils avaient modifié génétiquement une souche de maladie du charbon (Bacillus anthracis) de façon à la rendre insensible aux vaccins existant contre cette bactérie.
C’est pendant le même mois de décembre 1997 que le président américain Bill Clinton eut l’occasion de discuter longuement avec Craig Venter, un éminent spécialiste du décryptage du génome humain : lors de ce dîner dans une résidence luxueuse d’une petite île de Caroline du Sud, racontent trois journalistes du New York Times dans leur livre Germs, Venter expliqua au président que la connaissance des génomes "pourrait être extraordinairement dangereuse si elle se retrouvait dans de mauvaises mains". "Clinton, ajoutent-ils, demanda si la variole pourrait être combinée avec un autre agent nocif pour la rendre encore plus menaçante. Venter répondit que c’était possible."
Comment le génie génétique peut-il servir à mettre au point de nouvelles armes biologiques ? La liste des possibilités, décrite par les spécialistes, est désagréablement longue. On peut rendre pathogène une bactérie inoffensive et bien connue, telle Escherichia coli, en lui insérant des gènes de toxicité empruntés au génome de bactéries dangereuses. On peut modifier une bactérie pathogène, afin qu’elle ne soit pas reconnue par le système immunitaire ou que les vaccins existants soient inefficaces. On peut chercher à rendre l’agent insensible aux antibiotiques, ce qui rendrait la protection des populations ciblées difficile, voire impossible.
Ces techniques sont déjà pratiquement maîtrisées. Les spécialistes voient encore plus loin, comme le relate un article cosigné par Claire Fraser, la femme de Craig Venter, dans Nature Genetics du 22 octobre 2001 : par exemple, la possibilité d’introduire un virus "silencieux" dans le génome d’une population donnée, virus qui serait réveillé ultérieurement par un signal chimique. "L’idée, explique David Sourdive, un spécialiste français de l’étude des génomes, est de réaliser une arme ciblée sur une population choisie et préalablement "marquée" par un virus."
"En fait, dit un expert de la délégation générale pour l’armement, il n’y a rien en biologie qui ne soit transposable sur le plan militaire." Le décryptage et la publication des génomes deviennent une source d’inquiétude majeure : le danger est en effet que l’on puisse reconstituer le virus à partir de sa séquence, ou tout du moins repérer les zones de virulence, cloner ces gènes et les transférer dans un autre organisme. Le directeur du centre HKU Pasteur, Antoine Danchin, regrette ainsi que l’on ait publié la carte génétique du virus de la variole en 1992. "Ne pouvait-on imaginer, dit-il, que ce qui est simple pour des laboratoires bien outillés, reconstruire un virus à partir de sa séquence, l’est aussi pour des laboratoires mal intentionnés ?"
"QUI A LE DROIT DE SAVOIR ?"
Mais de telles voix sont isolées : en octobre dernier, le centre britannique Sanger a fièrement annoncé le décryptage du génome de Yersinia pestis, la bactérie responsable de la peste noire. Une publication diversement appréciée par les toxicologues, alors que des souches résistant à tout antibiotique ont été repérées à Madagascar. "Mais on ne peut pas ne pas publier les résultats, dit Michèle Mock, spécialiste de la maladie du charbon à l’Institut Pasteur. Et puis sur la base de quels critères déterminer qui a le droit de savoir ?"
De nombreux spécialistes craignent davantage une autre forme de bioterrorisme : celle qui ciblerait l’agriculture. "Des armes tournées vers la production agricole seraient beaucoup plus efficaces, dit David Sourdive. D’abord, l’effet de déstabilisation d’une maladie agricole est garanti et bien connu : voyez par exemple ce qui s’est passé avec la fièvre aphteuse en 2001. Et puis l’agriculture est plus vulnérable parce qu’elle présente beaucoup moins de diversité génétique que les populations humaines." Le travail sur les maladies agricoles était déjà un des principaux programmes de recherche d’armes biologiques pendant la guerre froide, tant aux Etats-Unis qu’en URSS.
Outre son efficacité, ce type de recherche présente un autre avantage : il est beaucoup plus discret. Comment distinguer un laboratoire agronomique d’un laboratoire militaire ? Enfin, les OGM agricoles présentent certains points communs avec les agents bactériologiques militaires : ainsi la bactérie Bacillus thuringiensis, qui est un des outils les plus utilisés par les firmes de biotechnologie végétale, est un cousin très proche de Bacillus anthracis, l’agent de la maladie du charbon, dont il constitue un très bon modèle.
La question de l’emploi de l’arme biologique n’appartient plus, depuis quelques années, à la pure spéculation : dans le cadre de leur lutte contre la drogue, les Etats-Unis tentent depuis 1997 de faire accepter l’utilisation d’un champignon, Fusarium oxysporum, qui détruit la plante d’où l’on extrait la cocaïne. Une version génétiquement modifiée de ce champignon existe en laboratoire. Les Etats-Unis voulaient l’utiliser en Colombie, même si, selon des mouvements écologistes comme le Sunshine Project, ce champignon pourrait avoir des effets dévastateurs sur la biodiversité très riche des terres colombiennes : devant l’opposition qui s’est levée en Amérique latine et en Europe, ils ont pour l’instant repoussé l’utilisation du champignon. Mais jusqu’à quand ? A l’autre bout du monde, en Asie centrale, ils étudient aussi, dans un laboratoire de Tachkent, en Ouzbékistan, un champignon capable de s’attaquer au pavot, largement cultivé dans la région et notamment en Afghanistan. Si les opinions publiques n’y prennent garde, la guerre agrobiologique est à deux doigts de se banaliser, tandis que la guerre biologique - devrait-on dire biotechnologique ? - est redevenue une possibilité sérieuse.
Hervé Kempf
Source : internationalnews